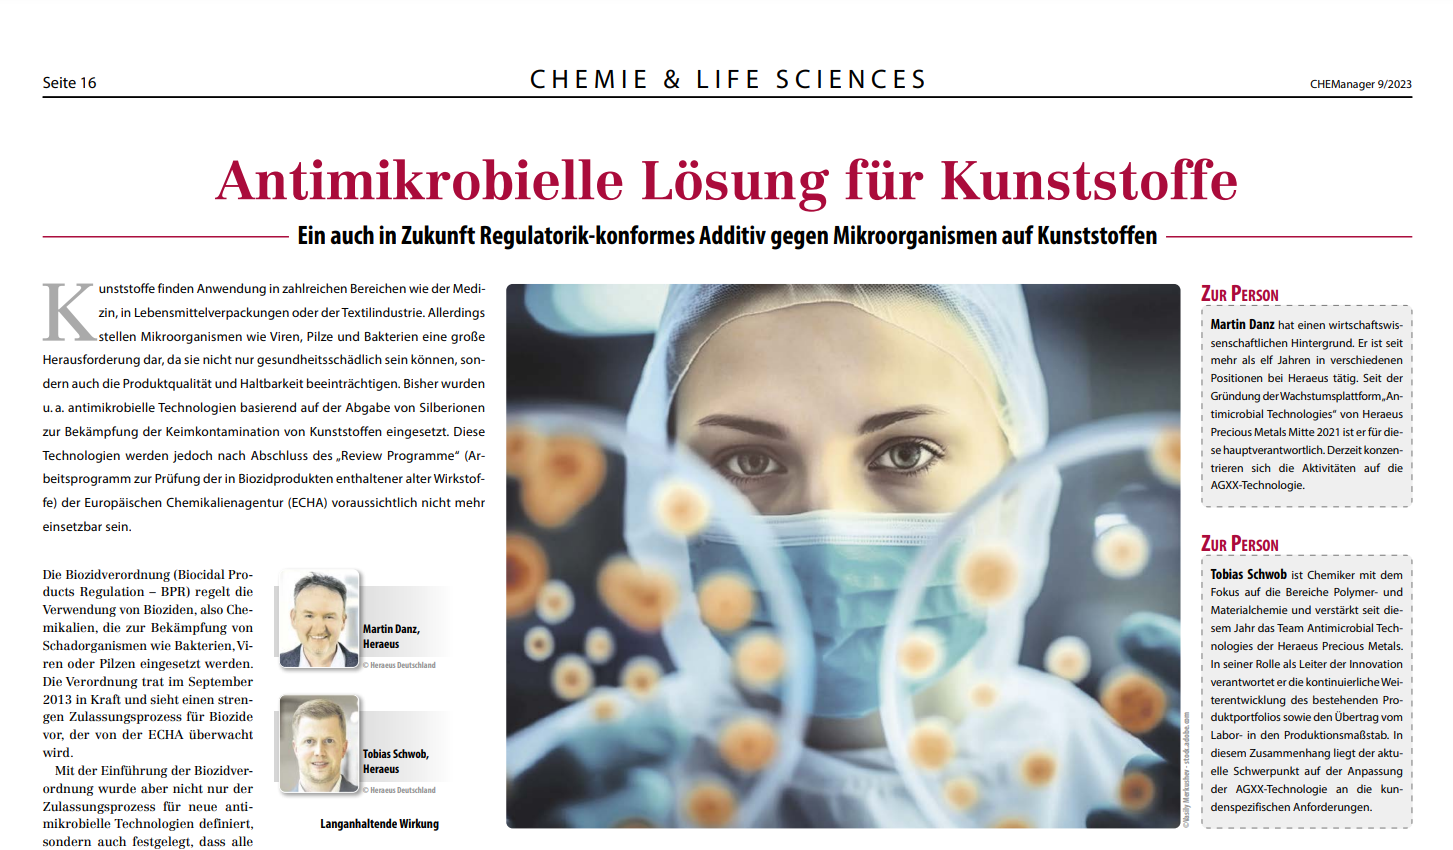

Kunststoffe finden Anwendung in zahlreichen Bereichen wie der Medizin, in Lebensmittelverpackungen oder der Textilindustrie. [...] Bisher wurden u. a. antimikrobielle Technologien basierend auf der Abgabe von Silberionen zur Bekämpfung der Keimkontamination von Kunststoffen eingesetzt. Diese Technologien werden jedoch nach Abschluss des „Review Programme“ (Arbeitsprogramm zur Prüfung der in Biozidprodukten enthaltener alter Wirkstoffe) der Europäischen Chemikalienagentur (ECHA) voraussichtlich nicht mehr einsetzbar sein.